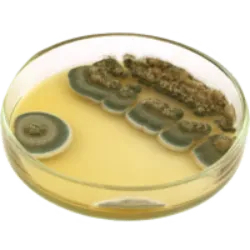

A descoberta da penicilina: uma revolução na medicina
A descoberta da penicilina: uma revolução na medicina. Em 1929, por um golpe de sorte, Alexander Fleming encontrou o primeiro antibiótico, a penicilina
Durante a Segunda Guerra Mundial, seu potencial foi amplamente testado, salvando inúmeras vidas. Noel Rosa e muitos outros artistas poderiam ter sido salvos da tuberculose se essa descoberta tivesse ocorrido antes.
O curioso é que Fleming, um pesquisador dedicado às bactérias, deixou uma placa de cultivo esquecida durante o verão. Por acaso, algumas migalhas de pão caíram sobre ela, criando fungos. Quando seu colega Merlin Pryce notou algo estranho nas placas prestes a serem descartadas, Fleming percebeu que os fungos tinham eliminado as bactérias, dando origem à penicilina, um marco na história da medicina.











